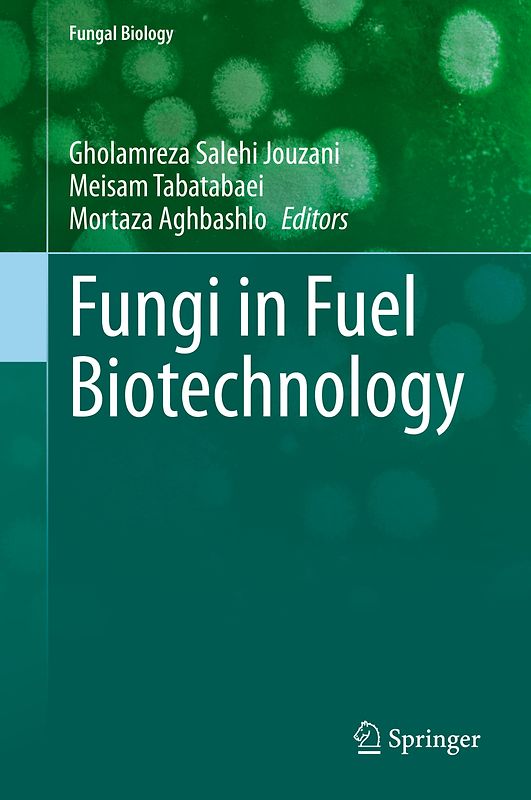
Fungi in Fuel Biotechnology

Derzeit nicht verfügbar
Handgeprüfte Gebrauchtware
Bis zu 50 % günstiger als neu
Der Umwelt zuliebe
Optischer Zustand
Beschreibung
Due to the huge quantity and diverse nature of their metabolic pathways, fungi have great potential to be used for the production of different biofuels such as bioethanol, biobutanol, and biodiesel. This book presents recent advances, as well as challenges and promises, of fungal applications in biofuel production, subsequently discussing plant pathogenic fungi for bioethanol and biodiesel Dieses Produkt haben wir gerade leider nicht auf Lager.
Handgeprüfte Gebrauchtware
Bis zu 50 % günstiger als neu
Der Umwelt zuliebe
Technische Daten
Erscheinungsdatum
28.10.2020
Sprache
Englisch
EAN
9783030444877
Herausgeber
Springer International Publishing
Serien- oder Bandtitel
Fungal Biology
Sonderedition
Nein
Seitenanzahl
233
Auflage
1st edition 2020
Einbandart
Gebundene Ausgabe
Autorenporträt
Dr. Gholamreza Salehi Jouzani is a Professor of Microbial Biotechnology at the Microbial Biotechnology Department of Agricultural Biotechnology Research Institute of Iran (ABRII). His research focus is agricultural microbial bio-products and biorefinery, including biofuels from biomass, biocompost, biopesticides, biofertilizers, and probiotics. Professor Salehi Jouzani has co-authored more than 100 peer-reviewed journal articles and book chapters, achieved more than 8 patents, and transferred two technologies to the private sector (h-index: 20, i10-index: 32). His publications have received 2221 citations. He has supervised more than 60 graduate students. In addition, he serves on the editorial board of several reputed journals including the Bioengineered (Taylor & Francis Online), Iranian Journal of Biotechnology, and Iranian Journal of Microbiology.
Schlagwörter
biofuel, Bioethanol, Biodiesel, Life cycle assessment, Consolidated bioprocessing, Volatile organic compound, Plant pathogenic fungi, VOCs, Plant probiotic fungi, Endophytic fungi, Gut fungi, Thermodynamics, Advanced modeling
Thema-Inhalt
PSQ - Mykologie, Pilze
PST - Botanik und Pflanzenwissenschaften
TCB - Biotechnologie
PSG - Mikrobiologie (nicht-medizinisch)
THV - Alternative und erneuerbare Energiequellen und -technik
PS - Biologie, Biowissenschaften
PDN - Wissenschaftliche Ausstattung, Experimente und Techniken
PSTB - Pflanzenbiologie
Höhe
235 mm
Breite
15.5 cm
Hersteller: Springer, Europaplatz 3, Heidelberg, Deutschland, 69115, ProductSafety@springernature.com, Springer Nature Customer Service Center GmbH
-.-
Leider noch keine Bewertungen
Leider noch keine Bewertungen
Sicher bei rebuy kaufen
Schreib die erste Bewertung für dieses Produkt!
Wenn du eine Bewertung für dieses Produkt schreibst, hilfst du allen Kund:innen, die noch überlegen, ob sie das Produkt kaufen wollen. Vielen Dank, dass du mitmachst!
Sicher bei rebuy kaufen

